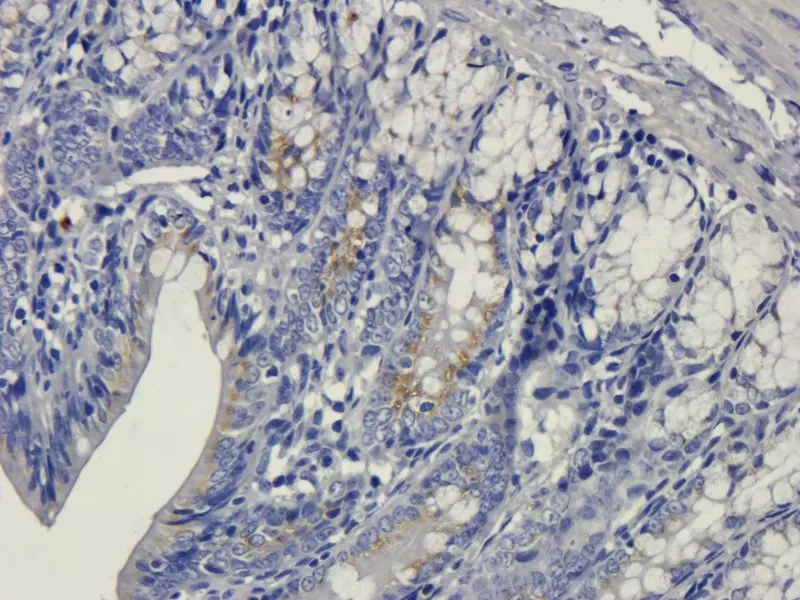
IHC-P Vegfa

You have no items in your shopping cart.
Immunohistochemistry Tips and Tricks
9 Tips to Successful Immunohistochemistry
Immunohistochemistry (IHC) is an invaluable tool for researchers in clinical settings and laboratories. A combination of IHC techniques results in clear imaging of specific tissue components. Labeled antibodies are used to bind to specific target antigens in situ and combined with optimized staining, cells and components are visualised with clarity. IHC can provide accurate data revealing distribution, quantity and intensity of expression to enhance and validate your research. Your protocol design will affect your results, the choices within the protocol will impact the quality of the results you achieve. Use Biorbyt’s experience, along with our vast range of high quality products, to support your research at every stage.
Applications of Immunohistochemistry
IHC is used by researchers globally to diagnose disease, in drug development and in a wide range of biological research. Identification of cells, components, their origins and pathology can be visualised in glorious colour using IHC in isolation or combined with other techniques. Cellular activity in response to specific chemicals can be observed and quantified to understand efficacy during drug development. Modern IHC techniques allow high-throughput, multiparametric, accurate data analysis at all levels of research.
The basic steps of immunohistochemistry are:
Obtain your tissue sample treated by formalin-fixing and embedding in paraffin or flash-freezing.
Incubate with an antibody specific to the protein you are studying.
Use a chromogenic substrate or fluorescent dye to detect signal viewed using light or fluorescence microscopy.
This sounds straightforward but there are many pitfalls to avoid. Optimizing your IHC protocol will save valuable time and money and produce reliable results. Biorbyt have a wealth of knowledge and experience alongside the perfect solutions to guide your protocol. We are constantly developing our product range to keep you at the forefront of research and our experts are here to support you. Access our in-depth protocol guide sheet. Our protocol optimization advice service can help you tailor your protocol to your specific research and we can recommend positive controls for a more robust research outcome.
IHC Protocol Tips
-
Choose the right antibody and Test it
Review the validated applications listed for the antibodies you are considering, our datasheets will help you. Optimally, your selection should be an antibody that is validated in IHC. Choosing antibodies without IHC validation will introduce an element of risk. To help inform your choices, when selecting antibodies from Biorbyt we make it clear whether the product has been validated in paraffin (IHC-P) or in frozen section (IHP-Fr) and whether it is validated in Western Blot (WB). Biorbyt’s team can recommend which species have been tested and advise you whether a particular antibody might work in a different species based on sequence identity to the immunogen. If required, we will run the blast and make a recommendation. Once selected, you will need to test the antibody at different concentrations to establish the correct antibody concentration for your experiment. Because diluent choice will affect antibody performance, Biorbyt’s diluents are specifically matched to given antibodies to make things easier.
-
Preparation of Tissue
Either by freezing or fixing in formalin and embedding in paraffin. Your choice is important as both IHC-P and IHP-Fr methods will affect your tissue, there are pros and cons to each method. Freezing tissue will result in morphological changes while embedding in paraffin will cause some shrinkage, creating a falsely high density of antigens. If your tissue section was frozen, we would recommend utilising cryostat for smooth sectioning. If embedded in paraffin, a microtome would be the method of choice, your section needs to be as uniform as possible.
-
Control
The validity and importance of these cannot be emphasised enough. Carrying out controls will lead to a more robust research outcome and make it easy to troubleshoot when unexpected results arise. At every opportunity within your experiment, controls will improve confidence in your data and enable you to see results of interest more clearly. You, and your audience will have more confidence in your results if controls were used well throughout experimentation. Biorbyt are happy to recommend positive controls to include in your protocol.
-
Tissue Fixation
The solution and methods you choose will affect the quality of staining achieved. The methodology you choose will be dictated by the tissue type, its age as well as the target antigen. Research which methods will suit your sample, factors to consider include: the type and concentration of fixative used, length of time of fixation, pH as well as which additives are used if any. Again, Biorbyt can provide advice.
-
Antigen Retrieval
Important to get this right to achieve a good quality staining. Your tissue will need to be treated either with heat or using enzymes to allow your antibody to access your antigen. The use of heat could create artificial changes to your tissue so an appropriate control procedure should be set up alongside. The process of fixation can mask the antigen making binding impossible. In most cases, heating the tissue in an acidic buffer solution is less likely to affect the integrity of the antigen of interest. Biorbyt can guide you, we have the benefit of experience and feedback from our research community about what works best. Ultimately, a good antigen retrieval results in the best staining. Repetition of this stage should also include using an alkaline antigen retrieval buffer.
-
Blocking
This is the process of blocking unwanted components that your tissue might express such as biotin, alkaline phosphatase and peroxidase which can affect your results. Biotin detection systems could detect endogenous biotin and to avoid this you will need to implement a biotin blocking system. Similarly, if using horseradish peroxidase (HRP) or alkaline phosphatase conjugated secondary antibodies, peroxidases and alkaline phosphatase may be expressed leading to misleading results. To avoid this you should use an IHC tissue primer, Biorbyt can advise you of the best choice to suit your protocol.
-
Non-specific Binding
Fc receptors, among others, can cause non-specific binding by your antibody. Blocking of these receptors can be done before incubation with the primary antibody. It is important to use a serum from the same species as that used to raise your secondary antibody. Another option is to use an IHC background blocker which will decrease the background signal. This can also be achieved by increasing the blocking time.
-
Detection System Choice
There are a range of systems available to detect the location and abundance of your protein using a fluorescent dye or chromogenic substrate. For IHC the most frequently used systems are streptavidin-biotin and avidin-biotin. The methodology you have used throughout will influence the effectiveness of your detection system. Perfect methodology could be wasted by the use of a detection system that will not display the results to their full potential. Your choice will depend on your target and its level of expression. Direct detection methods utilise labeled primary antibodies. With indirect detection the primary antibody is unlabeled and a labeled secondary antibody is used that has been raised against the host species of the primary antibody. This indirect method is more commonly used in IHC. Conjugated secondary antibodies can amplify signals so are the preferred option if proteins are of low abundance. If you do have high levels of protein expression, conjugated primaries are a better choice. Your choice of method will depend on your methodology, Biorbyt can provide guidance according to your individual protocol.
-
Staining
To achieve an intensity and accuracy of staining, your choice of chromagen needs to be perfect for the tissue section, the target, any other stains being used and the mounting media. As well as staining, counterstaining will increase contrast and perspective. Our wide range of chromogens is designed to provide solutions for every set-up. We know what works best and will be able to recommend the optimum solutions to maximize the hard work you have already put in.